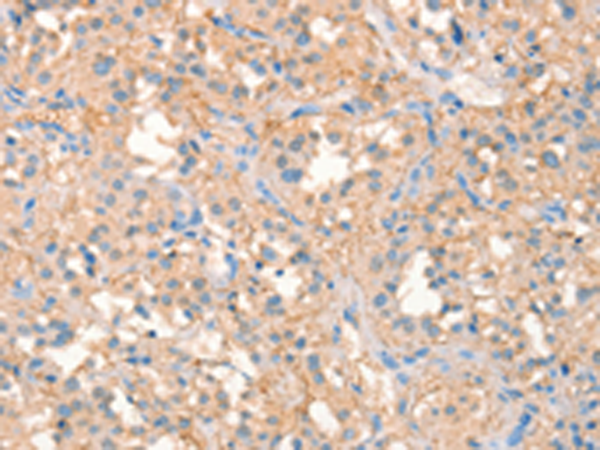

|
Background: |
Voltage-gated potassium (Kv) channels represent the most complex class of voltage-gated ion channels from both functional and structural standpoints. Their diverse functions include regulating neurotransmitter release, heart rate, insulin secretion, neuronal excitability, epithelial electrolyte transport, smooth muscle contraction, and cell volume. Four sequence-related potassium channel genes - shaker, shaw, shab, and shal - have been identified in Drosophila, and each has been shown to have human homolog(s). This gene encodes a member of the potassium channel, voltage-gated, shab-related subfamily. This member is a delayed rectifier potassium channel and its activity is modulated by some other family members. |
|
Applications: |
ELISA, IHC |
|
Name of antibody: |
KCNB1 |
|
Immunogen: |
Synthetic peptide of human KCNB1 |
|
Full name: |
potassium voltage-gated channel subfamily B member 1 |
|
Synonyms: |
DRK1; Kv2.1 |
|
SwissProt: |
Q14721 |
|
ELISA Recommended dilution: |
5000-10000 |
|
IHC positive control: |
Human liver cancer |
|
IHC Recommend dilution: |
25-100 |
購物車
幫助
021-54845833/15800441009
